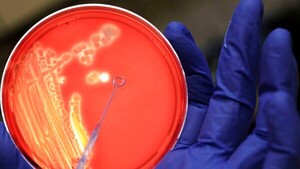

- Inicio
- acinetobacter


El contacto fugaz de este insecto puede tener consecuencias preocupantes para la salud. Foto: istockphoto
[Leer más]
Julio 03, 2025

Redacción Ciencia, 3 ene (EFE).- El desarrollo de un nuevo tipo de fármaco contra una especie bacteriana resistente a varias clases de antibióticos ya existentes ha dado resultados prometedores en ensayos con ratones y ahora se prueba en humanos, según...
[Leer más]
Enero 03, 2024

La contaminación por plástico daña gravemente los ecosistemas de los ríos, y desde ahora hay más evidencias de su riesgo para la salud humana: los científicos descubrieron que estos desechos alberg…
[Leer más]
Noviembre 01, 2023

La contaminación por plástico daña gravemente los ecosistemas de los ríos, y desde ahora hay más evidencias de su riesgo para la salud humana: los científicos descubrieron que estos desechos albergan todo un reservorio de bacterias nocivas y de genes r...
[Leer más]
Noviembre 01, 2023

Madrid, 1 nov (EFE).- La contaminación por plástico daña gravemente los ecosistemas de los ríos, y desde ahora hay más evidencias de su riesgo para la salud humana: los científicos descubrieron que estos desechos albergan todo un reservorio de bacteria...
[Leer más]
Noviembre 01, 2023
Internacionales

Barcelona (España), 19 may (EFE).- Investigadores de la Universidad de Pensilvania (EE.UU.) y del Instituto de Bioingeniería de Cataluña (IBEC) desarrollaron nanorrobots autónomos y con actividad antimicrobiana capaces de atacar a las bacterias en el s...
[Leer más]
Mayo 19, 2022
Internacionales


Emiten alerta por resistencia anti microbiana a todos los laboratorios del país
[Leer más]
Julio 13, 2021
Nacionales

Ante el incremento de bacterias resistentes a antibióticos en los hospitales del país, el Laboratorio Central de Salud Pública insta a todos los servicios de Microbiología a remitir entre el 10 y 15% de los aislamientos de muestras clínicas, de Pseudom...
[Leer más]
Julio 12, 2021